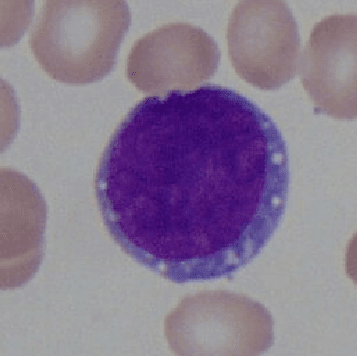
Figure 1 for Quaternion-Valued Convolutional Neural Network Applied for Acute Lymphoblastic Leukemia Diagnosis

Abstract:The field of neural networks has seen significant advances in recent years with the development of deep and convolutional neural networks. Although many of the current works address real-valued models, recent studies reveal that neural networks with hypercomplex-valued parameters can better capture, generalize, and represent the complexity of multidimensional data. This paper explores the quaternion-valued convolutional neural network application for a pattern recognition task from medicine, namely, the diagnosis of acute lymphoblastic leukemia. Precisely, we compare the performance of real-valued and quaternion-valued convolutional neural networks to classify lymphoblasts from the peripheral blood smear microscopic images. The quaternion-valued convolutional neural network achieved better or similar performance than its corresponding real-valued network but using only 34% of its parameters. This result confirms that quaternion algebra allows capturing and extracting information from a color image with fewer parameters.